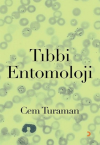
Tıbbi Entomoloji

Sağlık Değerlendirme Metodu

Kitap, onbeş yıldan uzun bir zamana yayılan, literatür tarama, seminer, kurs ve konferans malzemesinin, nebülöz biçimde birikmesiyle şekillenmiş, içeridekilerin çekerek getirdiği yeni kavramların da, bu girdaba sürüklenmesiyle, her biri ortalama beşer bölümden oluşan dört temel kısım ortaya çıkmıştır.
Bu kısım ve bölümleri birbirine, tartışılan konu hakkında, kitapta farklı yerlerde bulunan bilgiye işaret eden dipnotlarla bağlanmıştır.
Kitap, onbeş yıldan uzun bir zamana yayılan, literatür tarama, seminer, kurs ve konferans malzemesinin, nebülöz biçimde birikmesiyle şekillenmiş, içeridekilerin çekerek getirdiği yeni kavramların da, bu girdaba sürüklenmesiyle, her biri ortalama beşer bölümden oluşan dört temel kısım ortaya çıkmıştır.
Bu kısım ve bölümleri birbirine, tartışılan konu hakkında, kitapta farklı yerlerde bulunan bilgiye işaret eden dipnotlarla bağlanmıştır.
| Taksit Sayısı | Taksit tutarı | Genel Toplam |
|---|---|---|
| 2 | 76,24 | 152,48 |
| 3 | 52,58 | 157,75 |
| 6 | 27,08 | 162,45 |
| 9 | 18,68 | 168,15 |